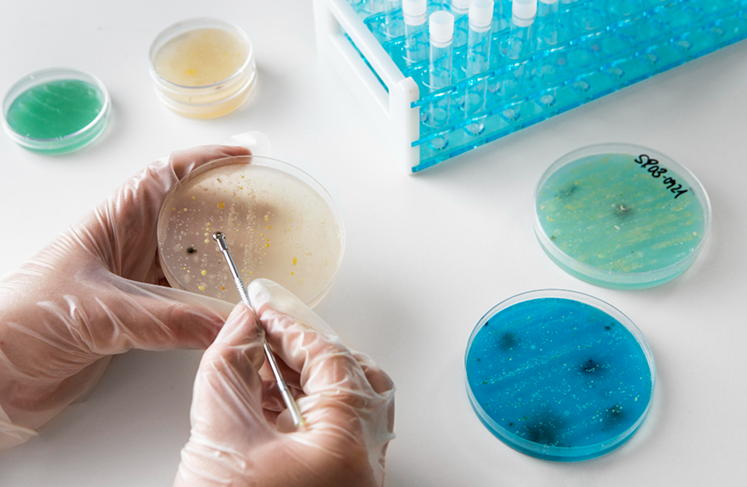
Micología

Laboratorio de Especialidades Médicas Ochoa
Somos un laboratorio de alta complejidad, comprometido con la excelencia, la precisión diagnóstica y la atención humana. Contamos con tecnología de vanguardia, personal altamente capacitado y procesos certificados que garantizan resultados confiables para médicos y pacientes.
Cada etapa junto a ti

Servicios de diagnóstico clínico que ofrecemos

Analítica General

Hormonas

Auto Inmunidad

Biología Molecular

Microbiología

Anatomía Patológica

Genética

Andrología
Micología
3400+
Pacientes atendidos en 1 mes
800+
Exámenes Disponibles
11
Puntos de atención
3
Ciudades
Nuestra política de calidad
En Laboratorio de Especialidades Médicas Ochoa & Ochoa, realizamos exámenes de diagnóstico clínico, garantizando la entrega de resultados oportunos, confiables y confidenciales, sustentado en un equipo profesional, experimentado y competente, que busca satisfacer las necesidades de los clientes, cumpliendo con los requisitos legales y la mejora continua del Sistema de Gestión de Calidad.

